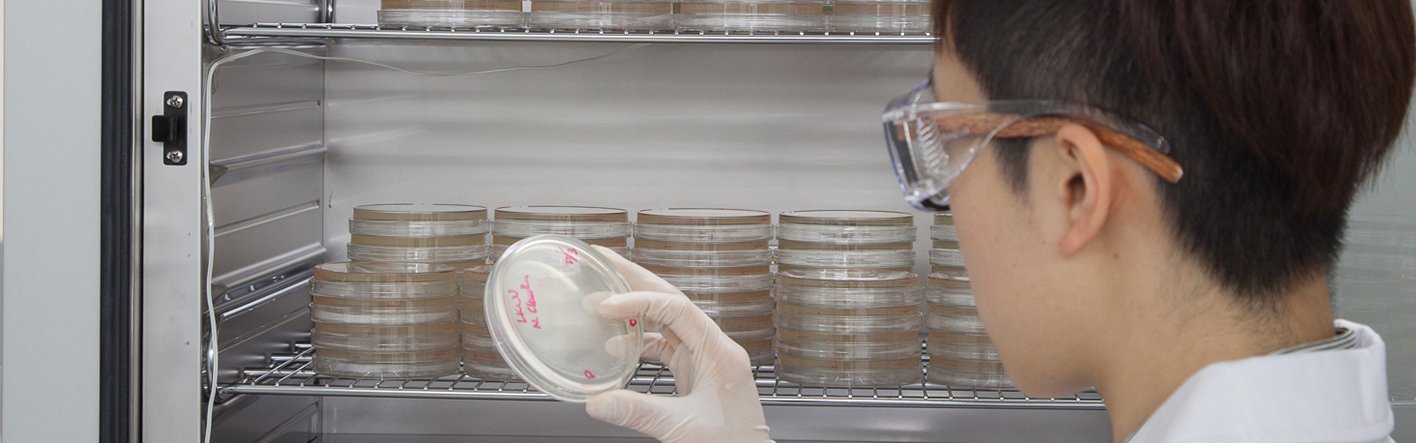

水質測試
-
食水及水塔水退伍軍人桿菌測試 (包括嗜肺軍團菌)
-
水中異養菌數 (總細菌數)
-
食水及海水中總大腸菌群
-
食水及海水中大腸桿菌
-
食水及海水中糞便大腸菌群
-
阿米巴變形蟲
-
水中金黃葡萄球菌
-
水中綠膿桿菌
-
水中霍亂弧菌
-
水樣本中的腸球菌
-
水樣本中的產氣莢膜梭狀芽孢桿菌
消費產品測試
-
濾水系統抗菌能力測試
-
紡織材料抗菌及抗真菌測試
-
塑料表面抗菌能力測試
-
消毒產品及消毒液的抗菌及抗真菌率測試
-
表面拭子試驗以確定衛生程度測試
-
一次性衛生用品(包括口罩)測試
-
化妝品微生物測試
浮游細菌採樣
-
室內環境總細菌數測試
-
室內環境總真菌數測試
工程實例
大腸桿菌
日期: 2024年7月至現在
支部: 微生物測試
項目: 為維多利亞港水質調查提供採樣和實驗室分析服務
客戶: 環境保護署
霍亂弧菌
日期: 2024年8月至現在
支部: 微生物測試
項目: 為魚類統營處提供海水細菌分析服務
客戶: 魚類統營處
退伍軍人桿菌測試
日期: 2025年1月至現在
支部: 微生物測試
項目: 提供香港教育大學校園內的水質採樣及檢測服務 (2025)
客戶: 香港教育大學
抗菌能力測試
日期: 2025年1月至現在
支部: 微生物測試
項目: 抗菌能力測試
客戶: 納米及先進材料研發院有限公司